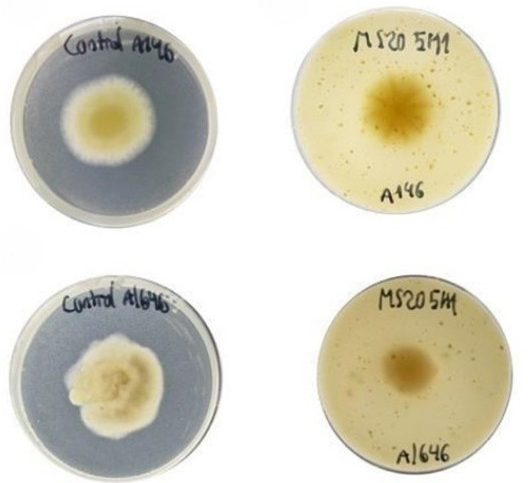

‘Actiurròs’ converteix residus agrícoles en envasos compostables que allarguen la vida útil dels aliments.
Ivace+i i la UV col·laboren amb Aimplas en un projecte que redueix el desaprofitament alimentari i fomenta l’economia circular.
L’objectiu és crear envasos per a productes carnis capaços d’ampliar fins a un 25 % la seua data de caducitat.
El projecte, denominat ‘Actiurròs’, desenvolupa un envàs compostable a partir de subproductes agrícoles i sense conservants químics.
La Conselleria d’Innovació, Indústria, Comerç i Turisme, que dirigeix Marian Cano, finança a través d’Ivace+i Innovació un projecte pioner que transforma residus de la indústria de l’arròs en compostos bioactius i cel·lulosa, materials útils per a fabricar envasos actius i sostenibles destinats al sector carni.
L’objectiu principal és substituir els components dels envasos de plàstic, difícils de reciclar, per materials respectuosos amb el medi ambient que, alhora, milloren la conservació dels aliments. D’esta manera, s’alinea amb els principis de l’economia circular que impulsa la Comissió Europea.
El projecte ‘Actiurròs’, liderat pel Laboratori de Biotecnologia Agroalimentària de la Universitat de València (UV) en col·laboració amb Aimplas, compta amb finançament europeu del programa FEDER Comunitat Valenciana 2021-2027.
A diferència dels envasos convencionals, este nou material serà 100 % compostable en condicions domèstiques, eliminarà l’ús de multicapes no reciclables i incorporarà compostos naturals obtinguts a partir de la fermentació de residus d’arròs que prolonguen la vida útil dels aliments.
Segons les previsions, els nous envasos permetran allargar fins a un 25 % la caducitat dels productes carnis frescos, cosa que es traduirà en una reducció estimada del 5 % del desaprofitament alimentari.
La iniciativa, que ja es troba en la seua fase final, conclourà amb la transferència de resultats a empreses arrosseres, fabricants d’envasos i distribuïdores de productes carnis, impulsant així solucions sostenibles en tota la cadena de valor.


